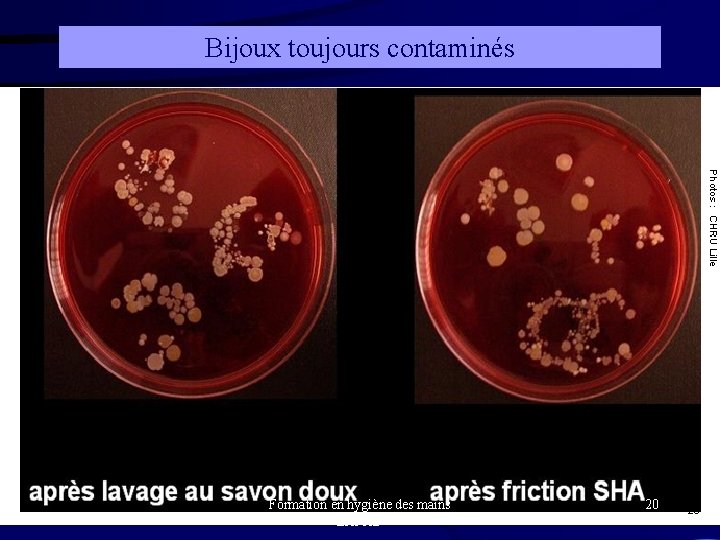
Bijoux toujours contaminés Formation en hygiène des mains EHPAD 20

L hygine des mains Formation en hygine des

- Slides: 24
L ’hygiène des mains Formation en hygiène des mains EHPAD 1
historique • Ignace Semmelweiss (1846) constatait à la maternité de Vienne que les parturientes examinées par des étudiants sortants de salle d’autopsie décédaient souvent de complications septiques du post partum. • Il en concluait que des particules cadavériques adhérant aux mains des étudiants possédaient la propriété d’engendrer des fièvres. • Il imposa alors à tous le lavage des mains avant de pratiquer les touchers vaginaux. • On vit la mortalité chuter de 12% à 2, 3%. • Donc les mains par leur seul contact pouvaient être infectantes. Formation en hygiène des mains EHPAD 2
Mesures de prévention = éviter la transmission des infections Environnement Dispositifs médicaux air, eau, aliments, objets, surfaces vasculaires, urinaires, trachéaux Malades Soignants (manuportage) Malades Formation en hygiène des mains EHPAD 3
Formation en hygiène des mains EHPAD 4
2 catégories de germes sont présentes sur les mains : • Notre propre flore cutanée. Il s’agit d’une flore commensale, bien ancrée, protectrice, théoriquement non pathogène pour un individu sain. C’est la flore résidente • Une flore de passage composée de germes pathogènes récoltée au gré des activités. Sa composition varie au cours des contacts (patient, environnement, objet…) C ’est la flore transitoire. Formation en hygiène des mains EHPAD 5
Hygiène des mains = élimination des souillures, de la flore transitoire et +/- réduire la flore résidente Comment ? • le lavage simple => souillures • la friction hydro-alcoolique => F. transitoire • Le lavage chirurgical réduction • La friction chirurgicale Formation en hygiène des mains EHPAD F. résidente 6
Formation en hygiène des mains EHPAD 7
Le lavage simple • Objectif : éliminer les souillures, les squames cutanés et réduire le nombre de bactéries constituant la flore transitoire des mains. • Quand : * En cas de souillures sur les mains, * à la prise de service * après les gestes de la vie quotidienne (aller aux toilettes, repas…) • Comment : * * * * Se mouiller les mains Prendre une (ou 2) dose(s) de savon doux, Savonner toute la surface des 2 mains pendant 30 s Rincer abondamment (20 à 30 s) Se sécher les mains avec essuie-mains UU Fermer le robinet Éliminer les essuie-mains dans la poubelle (pas de contact avec les mains) Formation en hygiène des mains EHPAD 8
Technique du lavage simple Lavage simple des mains avec un savon liquide doux Se mouiller les mains Essuyage par tamponnement du bas vers le haut Prendre une dose de savon Fermeture du robinet avec l’essuie-mains si commande manuelle Formation en hygiène des mains EHPAD Savonnage et rinçage environ 30 s chacun Jeter l’essuie-mains sans toucher la poubelle pour éviter la recontamination 9
Le lavage antiseptique • Objectif : éliminer la flore transitoire • Quand : avant et après tout patient en isolement, avant tout soin aseptique, avant tout geste invasif (ex : aspiration trachéale) • Comment : avec un savon antiseptique, savonner pendant au moins une minute toute la surface des 2 mains. Cette technique n’a plus d’indication aujourd’hui du fait d’une faible observance et d’un risque élevé de recontamination des mains, par rapport à la facilité et l’efficacité des SHA. Formation en hygiène des mains EHPAD 10
Les Produits Hydro-alcooliques (PHA) Formation en hygiène des mains EHPAD 11
Les solutions hydro-alcooliques Qu ’est-ce que c ’est? • Mélange : alcool + antiseptique (variable) + émollient • action bactéricide très rapide Formation en hygiène des mains EHPAD 12
Les solutions hydro-alcooliques comment s’en servir? • Sur des mains visuellement propres et non mouillées • Verser une dose dans le creux de la main et frictionner toute la surface des mains jusqu’au séchage complet (environ 30 secondes) • C’est tout! (ne pas rincer) • Se place dans les chambres, les salles de consultations, d ’examens, dans les poches, sur les chariots, …. Formation en hygiène des mains EHPAD 13
Paume contre paume Paume sur dos de la main (des 2 cotés) Paume contre paume doigts entrelacés Dos des doigts contre la paume opposée avec doigts emboîtés Pouce droit dans paume gauche et vice versa Extrémité des doigts dans la paume opposée (des 2 cotés) Poignets (des 2 cotés) Formation en hygiène des mains EHPAD 14
L’intérêt • • • Pas de point d’eau nécessaire plus rapide qu’un lavage simple n’immobilise pas beaucoup mieux toléré Efficacité +++ en 30 s Formation en hygiène des mains EHPAD 15
Les limites • Les SHA sont inutilisables si les mains sont – – souillées poudrées (gants) +/- si mouillées (les sécher au préalable) En cas d’infection à Clostridium difficile ou gale • Attention au risque d’ingestion par les patients (choix du conditionnent +++) • Pas de support mural fixe dans les couloirs (risque incendie) Formation en hygiène des mains EHPAD 16
INDISPENSABLE pour tout type d’hygiène des mains • SYSTEMATIQUE ENTRE CHAQUE PATIENT (précautions standard) • FAIT PARTIE DU SOIN Formation en hygiène des mains EHPAD 17
Pré requis à l’ hygiène des mains Recommandations SFHH 2009 Prévention de la transmission croisée - R 12 – ongles courts < 5 mm, sans vernis, faux ongles ou french manucure – sans bijoux (montre et alliance comprises) Formation en hygiène des mains EHPAD 18
Tolérance 0 bijou • TOUJOURS ENLEVER TOUS LES BIJOUX Formation en hygiène des mains EHPAD 19
Bijoux toujours contaminés Formation en hygiène des mains EHPAD 20
Efficacité comparée des techniques d’hygiène des mains Mains non souillées = flore résidente 1. Avant lavage 2 a. Savon doux 30 sec. 2 b. Savon antiseptique 30 sec 2 c. SHA 20 -30 sec. Le contrôle des germes à portée de mains Formation en hygiène des mains EHPAD 21
• Pour savoir plus : http: //www. sante-sports. gouv. fr/dossiers/sante/mission-mains-propres-2 -. html • recommandations pour l’HDM 2009 SFHH: http: //www. sfhh. net/telechargement/recommandations_hygienemain 2009. pdf Formation en hygiène des mains EHPAD 22
Les dérives !!! Les produits hydro-alcooliques ne doivent pas être utilisés pour la désinfection : l l du matériel (gants, sthétoscope, garrot…) des surfaces, ( mobilier, appareils…) des muqueuses, de la peau. Formation en hygiène des mains EHPAD 23
Les Normes Friction Hygiénique chirurgicale Bactéricidie EN 1040 Lévuricidie EN 1275 Normes d’application EN 1500 EN 12791 Virucidie, norovirus inclus (période épidémique), Rotavirus * EN 14476+1 Pas d’activité sporicide, mycobactéricide ou tuberculocide nécessaires http: //www. cclinparisnord. org/EHPAD/FAQ_PHA_EHPAD 2011. pdf Formation en hygiène des mains EHPAD 24